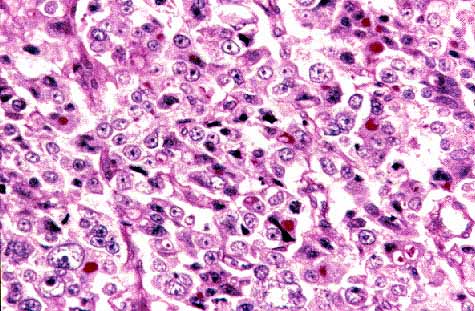
foto 5

PÛster
N∫ 073
PÛster |
Miguel Angel Limeres Gonz·lez, Pilar de la Rosa del Rey, Ana Alonso Fern·ndez-Aceytuno
|
| Foto n∫ 5: Presencia de material PAS positivo, resistente a la diastasa, en el citoplasma de las cÈlulas de las ·reas hepatoides. |
 |
| Foto n∫ 6: ExpresiÛn de alfa-fetoproteÌna en el citoplasma de las cÈlulas de las ·reas hepatoides. |
 |
| Foto n∫ 7: Vena ocupada por un trombo tumoral. |